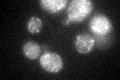
YPL029W

View description
ATP-dependent RNA helicase, component of the mitochondrial degradosome along with the RNase Dss1p; the degradosome associates with the ribosome and mediates turnover of aberrant or unprocessed RNAs
Localization:
Intensity:
Fold change:
Significance:
-
C’ GFP library in SD

mitochondria22.4 -
N' NOP1pr-GFP in SD

mitochondria52.8512 -
N' TEF2pr-mCherry in SD

mitochondria4.41816 -
N' NATIVEpr-GFP in SD

missing0 -
N' TEF2pr-VC and Cyto-VN in SD

#N/A0 -
C’ GFP library in SD+DTT
mitochondria23.671.05No -
C’ GFP library in SD+H2O2

mitochondria26.111.16No -
C’ GFP library in Starvation Media

mitochondria20.870.93No -
C’ GFP library on the background of Pup2-DaMP

mitochondria -
C’ GFP library on the background of CCT mutant

mitochondria27.1191.21004No
